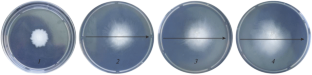

Abstract
Under stressful conditions, including infection with phytopathogens, plants produce various compounds that are growth activators, e.g., hydroxycinnamic acids (HAs), including ferulic acid (FA). The role of HAs in the relationship of plants and endophytic bacteria has not been studied in detail. The effect of FA at a concentration of 1.0–1000 μg/L on the reproduction and growth of the endophytic strain Bacillus subtilis 26D on agar and liquid media has been studied. It was found that FA suppressed and, at a lower concentration (0.7%), increased the size of bacterial colonies on an 1.5% agar medium. In a liquid medium, FA stimulated the multiplication of bacterial cells. It was shown that bacteria of the strain B. subtilis 26D are capable of FA destruction.

Similar content being viewed by others
REFERENCES
Kuramshina, Z.M., Smirnova, Yu.V., and Khairullin, R.M., Russ. J. Plant Physiol., 2016, vol. 63, no. 5, pp. 636–644.
Khare, E., Mishra, J., and Kumar, N.A., Front. Microbiol., 2018, vol. 15, Art. 02732. https://doi.org/10.3389/fmicb.2018.02732
De Oliveira, D.M., Finger-Teixeira, A., Mota, T.R., Salvador, V.H., Moreira-Vilar, F.C., Molinari, H.B.C., et al., Plant Biotechnol. J., 2015, vol. 13, pp. 1224–1232, Art. 12292. https://doi.org/10.1111/pbi.12292
Patzke, H. and Schieber, A., Food Res. Int., 2018, vol. 113, pp. 18–23. https://doi.org/10.1016/j.foodres.2018.06.062
Merkl, R., Hrádková, I., Filip, V., and Šmidrkal, J., Czech. J. Food Sci., 2010, vol. 28, pp. 275–279. https://doi.org/10.17221/132/2010-CJFS
Borges, A., Ferreira, C., Saavedra, M.J., and Simoes, M., Microb. Drug Resist., 2013, vol. 19, no. 4, pp. 256–265. https://doi.org/10.1089/mdr.2012.0244
Gurujeyalakshmi, G. and Mahadevan, A., Curr. Microbiol., 1987, vol. 16, no. 2, pp. 69–73.
Lopes, R., Tsui, S., Goncalves, P.J.R.O., and de Queiroz, M.V., J. Microbiol. Biotechnol., 2018, vol. 34, no. 7, Art. 94. https://doi.org/10.1007/s11274-018-2479-7
Nedorezkov, V.D., Biologicheskaya zashchita pshenitsy ot boleznei v usloviyakh Yuzhnogo Urala (Biological Protection of Wheat Against Diseases in the South Urals), Moscow: Mosk. S.-Kh. Akad., 2002.
Fall, R., Kearns, D.B., and Nguyen, T., BMC Microbiol., 2006, vol. 6, no. 1, Art. 31. https://doi.org/10.1186/1471-2180-6-31
Hamouche, L., Laalami, S., Lakkis, G., Kobaissi, A., Chokr, A., Putzer, H., and Hamze, K., Int. J. Sci. Technol. Res., vol. 4, no. 10, pp. 14–20.
Degrassi, G., de Laureto, P.P., and Bruschi, C.V., Appl. Environ. Microbiol., 1995, vol. 61, no. 1, pp. 326–332. https://doi.org/10.1128/AEM.61.1.326-332.1995
Wu, H., Haig, T., Pratley, J., Lemerle, D., and An, M., J. Chem. Ecol., 2000, vol. 26, pp. 2141–2154. https://doi.org/10.1023/A:1005520500110
Harshey, R.M., Annu. Rev. Microbiol., 2003, vol. 57, no. 1, pp. 249–273. https://doi.org/10.1146/annurev.micro.57.030502.091014
Henrichsen, J., Bacteriol. Rev., 1972, vol. 36, no. 4, pp. 478–503.
Cavin, J.F., Dartois, V., and Diviès, C., Appl. Environ. Microbiol., 1998, vol. 64, no. 4, pp. 1466–1471.
Tran, N.P., Gury, J., Dartois, V., Nguyen, T.K., Seraut, H., Barthelmebs, L., Gervais, P., and Cavin, J.F., J. Bacteriol., 2008, vol. 190, no. 9, pp. 3213–3224. https://doi.org/10.1128/JB.01936-07
Istasse, T., Jacquet, N., Berchem, T., Haubruge, E., Nguyen, B.K., and Richel, A., Anal. Chem. Insights, 2016, vol. 11, pp. 49–57. https://doi.org/10.4137/ACI.S39739
Salum, M.L. and Erra-Balsells, R., Environ. Control Biol., 2013, vol. 51, no. 1, pp. 1–10.
Zhao, Q., Trends Plant Sci., 2016, vol. 21, no. 8, pp. 713–721. https://doi.org/10.1016/j.tplants.2016.04.006
Johannes, C. and Majcherczyk, A., J. Biotechnol., 2000, vol. 78, no. 2, pp. 193–199. https://doi.org/10.1016/s0168-1656(00)00208-x
Dos, SantosW.D., Ferrarese, M.L.L., Nakamura, C.V., Mourao, K.S.M., and Mangolin, C.A., J. Chem. Ecol., 2008, vol. 34, pp. 1230–1241, Art. 1230. https://doi.org/10.1007/s10886-008-9522-3
Funding
The work was carried out within the state assignment (no. AAAA-A16-116020350027-7) with the equipment of the Biomika Center for Collective Use (Agidel Regional Center for Collective Use).
Author information
Authors and Affiliations
Corresponding author
Ethics declarations
The authors declare that they have no conflicts of interest. This article does not contain any studies involving humans and animals as objects.
Additional information
Translated by A. Ostyak
Rights and permissions
About this article
Cite this article
Sarvarova, E.R., Khairullin, R.M. & Maksimov, I.V. Effect of Ferulic Acid on the Colony Growth and Cell Reproduction of the Endophytic Bacterial Strain Bacillus subtilis 26D. Appl Biochem Microbiol 57, 508–513 (2021). https://doi.org/10.1134/S0003683821040141
Received:
Revised:
Accepted:
Published:
Issue Date:
DOI: https://doi.org/10.1134/S0003683821040141




